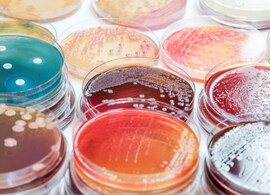
Change the way you control quality Change the way you control quality

Search
Search
Whether you prefer to make your own media, buy prepared plates, or take advantage of easy-to-prepare convenience formats, our culture medium expertise and rigorous quality standards have made us a preferred supplier and trusted source of prepared media to laboratories all around the world.
Find a variety of formats and sizes of atmosphere generating supplies to help you maximize incubation space and organism growth at the same time. All of our environmental solutions are designed to deliver the anaerobic, microaerophilic or CO2 conditions you need for microorganisms to thrive.
Protect the quality and safety of your finished products with a vast selection of high quality base products, supplements, and special blends, including a wide range of animal-free formulations. All of our dehydrated media is tested for quality and performance before, during, and after manufacturing to make sure our finished product meets the needs of your finished product.
Save time and labor with prepared media. Eliminate time consuming media preparation and achieve accurate, consistent results at every step of your workflow with a variety of high quality ready-prepared media plates and convenience formats.
Find your product mix for coronavirus viral transport and associated viral and bacterial infections.
#CoronavirusCare
Do you need to be more efficient and increase the productivity in your routine lab while reducing costs? Watch now to find out how Thermo Scientific™ Bi-plates can help address these challenges.
Our culture media experts share their top tips in five key areas of media preparation to help you ensure your culture media is fit-for-purpose for accurate and easily interpreted results.
Safeguarding the purity and identity of quality control organisms through proper maintenance is critical to achieving accurate control results for culture media and reagents. Our guide highlights industry guidelines and best practices to ensure compliance to standards, as well as approaches to reduce the time spent maintaining frozen stock cultures.
Enable quick and safe preparation of ATCC* and NCTC cultures for routine quality control testing with Thermo Scientific™ Culti-Loops™ direct-streak inoculating loops. Gel-preserved for enhanced viability and convenience.
Related products:
Have confidence in solutions that bring together the best in food quality and safety testing, and help you remain adaptive, responsive and competitive.
Identify infections and antimicrobial susceptibility quickly and accurately to guide optimal patient care with powerful manual and automated technologies, and a comprehensive line of media.